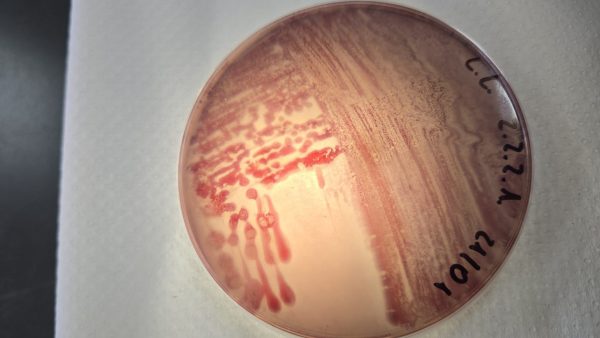
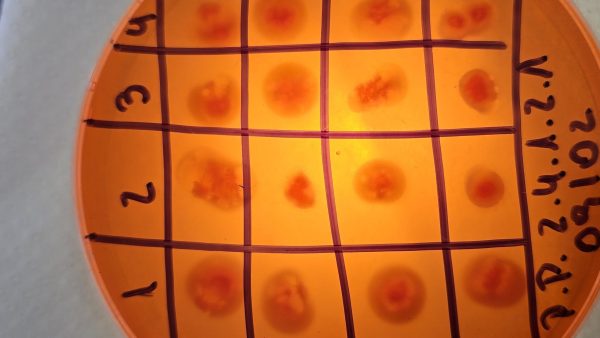

Esta innovación no solo mejora el crecimiento de las plantas, sino que actúa como un “escudo celular” que protege su capacidad de nutrirse y crecer bajo condiciones extremas. Los bioinoculantes son productos preparados en base a microorganismos benéficos como bacterias u hongos “buenos” para ayudar a las plantas a crecer de manera más saludable y natural.
Junto a un equipo de científicos, Cornejo ha logrado diseñar mezclas precisas de microorganismos —hongos, bacterias y levaduras— que trabajan en equipo en la raíz de la planta. Mientras los hongos extienden el alcance de las raíces para buscar agua, las bacterias y levaduras producen sustancias que regulan el crecimiento y activan las defensas naturales del vegetal.
Según el experto, la principal diferencia con los productos que existen en el mercado “es que se incluyen diversos grupos microbianos que no solamente por sí solos son capaces de promover el crecimiento vegetal, sino que en combinación no generan competencia y han sido desarrollados a nivel de especie desde un banco de microorganismos en continuo crecimiento”.
Resultados en terreno: Frutillas y lechugas más fuertes.
Las alternativas actualmente en el mercado no han sido validadas en general a un nivel de especie, buscando el microorganismo óptimo para su uso bajo condiciones de sequía.
Las investigaciones ya han demostrado resultados exitosos en cultivos clave:
Frutillas: El uso de estos consorcios permitió que las plantas mantuvieran su producción de frutos y mejoraran su estado nutricional a pesar de una reducción severa del riego. Incrementó el número de frutos en un 81.2% y la tasa fotosintética en un 80% bajo sequía severa.
Lechugas: Se logró un aumento del 43% en la biomasa de los brotes. Este efecto se atribuye a una reducción del daño oxidativo y un aumento en los niveles de prolina y pigmentos fotosintéticos.
Otra especie en la que están probando estos bioinoculantes es el trigo, en el que ya se cuenta con consorcios microbianos altamente efectivos, “que permitirá su cultivo en condiciones de mayor escasez hídrica como buena parte del centro-sur de Chile, donde su cultivo es predominante”.
El experto indica que “en el caso de la fruticultura, se puede promover en gran magnitud el acondicionamiento de portainjertos, que implique una mayor tolerancia a las condiciones de sequía u otras limitantes, incrementando el rendimiento y calidad de frutos, aspectos clave para su adecuada comercialización”.

Ciencia de vanguardia: protección de la fotosíntesis .
El hito más reciente, revelado mediante estudios de lipidómica, muestra que estos microorganismos protegen las membranas de los cloroplastos (donde ocurre la fotosíntesis). Al evitar que estas estructuras se degraden por la falta de agua, la planta puede seguir transformando la luz solar en energía, evitando el colapso que normalmente causaría la sequía.
“Los cloroplastos son los encargados de realizar la fotosíntesis, y por su papel principal en la captura de energía lumínica son los más afectados por la generación de compuestos oxidantes, que generan un estrés muchas veces representado por la destrucción de membranas a nivel celular”, explica el científico agregando que “esta ‘protección’ del tilacoide, que es la membrana que protege a los cloroplastos sugiere que la fotosíntesis se puede realizar incluso bajo condiciones de un alto estrés oxidativo”.
Este “traje a medida” microbiano, que ya está siendo validado en trigo y prontamente en tomates y frutales de carozo, representa un salto tecnológico hacia una agricultura más sostenible, capaz de asegurar la producción de alimentos en un futuro con cada vez menos agua.


